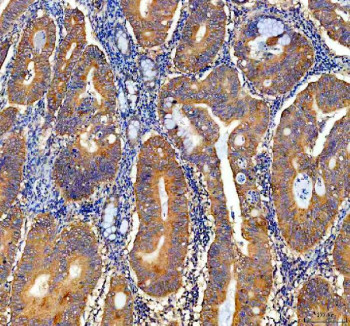
Anti-NQO1

Cookie preferences
This website uses cookies, which are necessary for the technical operation of the website and are always set. Other cookies, which increase the comfort when using this website, are used for direct advertising or to facilitate interaction with other websites and social networks, are only set with your consent.
Configuration
Technically required
These cookies are necessary for the basic functions of the shop.
"Allow all cookies" cookie
"Decline all cookies" cookie
CSRF token
Cookie preferences
Currency change
Customer-specific caching
FACT-Finder tracking
Individual prices
Selected shop
Session
Comfort functions
These cookies are used to make the shopping experience even more appealing, for example for the recognition of the visitor.
Note
Show the facebook fanpage in the right blod sidebar
Statistics & Tracking
Affiliate program
Conversion and usertracking via Google Tag Manager
Track device being used
| Item number | Size | Datasheet | Manual | SDS | Delivery time | Quantity | Price |
|---|---|---|---|---|---|---|---|
| NSJ-RQ8937 | 100 µg | - | - |
3 - 10 business days* |
790.00€
|
If you have any questions, please use our Contact Form.
You can also order by e-mail: info@biomol.com
Larger quantity required? Request bulk
You can also order by e-mail: info@biomol.com
Larger quantity required? Request bulk
0.5mg/ml if reconstituted with 0.2ml sterile DI water. NAD(P)H:quinone oxidoreductase 1 (NQO1) is... more
Product information "Anti-NQO1"
0.5mg/ml if reconstituted with 0.2ml sterile DI water. NAD(P)H:quinone oxidoreductase 1 (NQO1) is a cytosolic flavoprotein that plays a central role in cellular defense against oxidative stress. As a 2-electron reductase, NQO1 catalyzes the reduction of quinones to hydroquinones, thereby preventing the formation of reactive oxygen species through redox cycling. This detoxifying activity contributes to the maintenance of redox homeostasis and protection of cells from oxidative damage. Research with an NQO1 antibody has provided valuable insights into its functions in normal physiology and disease. NQO1 expression is regulated by the Nrf2 pathway and is upregulated under stress conditions as part of the antioxidant response. Elevated levels of this enzyme have been reported in various cancers, suggesting a dual role in both cytoprotection and tumor progression. Studies using an NQO1 antibody have linked the protein to drug metabolism, chemoresistance, and its potential as a therapeutic target. Beyond oncology, NQO1 has been studied in relation to cardiovascular disease, neurodegeneration, and aging. The enzyme also stabilizes certain proteins by protecting them from proteasomal degradation, further highlighting its regulatory importance in cell survival pathways. Given these diverse roles, the use of an NQO1 antibody is valuable for detecting protein expression across tissues, evaluating stress responses, and exploring disease-specific alterations. NSJ Bioreagents offers high-quality NQO1 antibody reagents designed for applications including western blot, immunohistochemistry, and immunofluorescence, enabling researchers to further define the biological significance of this multifunctional protein.
| Keywords: | Anti-NQO1, Anti-Azoreductase, Anti-DT-diaphorase, Anti-Quinone reductase 1, Anti-Menadione reductase, Anti-Phylloquinone reductase, Anti-NAD(P)H:quinone oxidoreductase 1, Anti-NAD(P)H dehydrogenase [quinone] 1, NQO1 Antibody |
| Supplier: | NSJ Bioreagents |
| Supplier-Nr: | RQ8937 |
Properties
| Application: | WB, IF, IHC (paraffin), FC |
| Antibody Type: | Polyclonal |
| Conjugate: | No |
| Host: | Rabbit |
| Species reactivity: | human |
| Immunogen: | Amino acids M1-K274 from the human protein |
| Format: | Purified |
Database Information
| KEGG ID : | K00355 | Matching products |
| UniProt ID : | P15559 | Matching products |
| Gene ID : | GeneID 1728 | Matching products |
Handling & Safety
| Storage: | +4°C |
| Shipping: | +4°C (International: +4°C) |
Caution
Our products are for laboratory research use only: Not for administration to humans!
Our products are for laboratory research use only: Not for administration to humans!
Information about the product reference will follow.
more
You will get a certificate here
Viewed